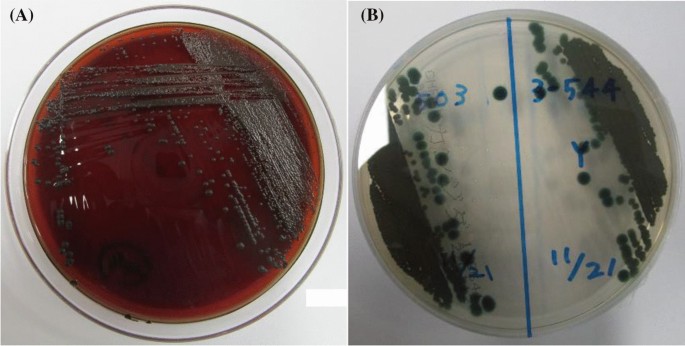
figure 2

- Case report
- Open access
- Published:
Multidisciplinary management of disseminated Exophiala dermatitidis mycosis in an infant with mixed phenotype acute leukemia: a case report
BMC Infectious Diseases volume 22, Article number: 797 (2022)
Abstract
Background
Exophiala dermatitidis is a dematiaceous fungus isolated from various environmental sources. Systemic E. dermatitidis infections can lead to fatal outcomes, and treatment has not yet been standardized. Although E. dermatitidis is also known to cause cutaneous infection, it has not been previously reported to appear as ecthyma gangrenosum (EG), an uncommon cutaneous lesion in neutropenic patients that is mainly caused by Pseudomonas aeruginosa.
Case presentation
A 2-month-old male infant with mixed-phenotype acute leukemia presented with prolonged fever unresponsive to antibacterial and antifungal agents during myelosuppression due to remission induction therapy. He also presented with skin lesions on the left wrist and left lower quadrant of the abdomen. The abdominal lesion gradually turned black and necrotic, which was consistent with the findings of the EG. E. dermatitidis was isolated from the blood, stool, wrist skin, and endotracheal aspirate. During hematopoietic recovery, consolidation in both lungs was evident. Multiagent antifungal treatment failed to eliminate E. dermatitidis from blood. In order to salvage the central venous catheter, ethanol lock therapy (ELT) was adopted, following which the blood culture became negative. The abdominal lesion that evolved as a necrotic mass connecting the small intestine and subcutaneous tissue adjacent to the skin was surgically resected. After these interventions, the general condition improved.
Conclusion
Disseminated E. dermatitidis mycosis in the neutropenic infant was successfully managed with a multidisciplinary treatment consisting of multiagent antifungal treatment, ELT, and surgery.
Background
Exophiala species are dematiaceous fungi characterized by their dimorphic character, switching from a yeast-like to a hyphal state. These species are distributed worldwide and has been isolated from humid environments such as soil, dishwashers, saunas, and bathrooms [1]. Among Exophiala species, E. dermatitidis is the most common human pathogen causing phaeohyphomycosis, an infection caused by several dark, melanin-pigmented dematiaceous fungal species. Phaeohyphomycosis is rare but remains important because of the ability to cause serious diseases such as dermatitis, pneumonia, cerebral abscess, and fungemia [2, 3].
Ecthyma gangrenosum (EG) is an uncommon cutaneous infection that occurs in critically ill, immunocompromised, or neutropenic patients. EG initially manifests as macular erythematous lesions that later become hemorrhagic and transform into tender erythematous areas with necrotic centers. Pseudomonas aeruginosa has been reported to be responsible for 70–90% of EG [4, 5], and the remaining cases are due to other microorganisms such as Aeromonas hydrophila [6] and Fusarium oxysporum [7]. Although E. dermatitidis is also known to cause cutaneous infections, it has not been reported as a causative agent of EG.
Herein, we report a case of mixed-phenotype acute leukemia (MPAL) who developed phaeohyphomycosis accompanied with fungemia, EG, and pneumonia due to E. dermatitidis during profound myelosuppression.
Case presentation
A previously healthy 2-month-old male infant showed poor feeding and had fever. The abdomen was distended, the liver was palpated 5 cm below the right costal margin, and the spleen was palpated 5 cm below the left costal margin. Laboratory findings were as follows: white blood cell count 439 × 109/L (neutrophils 0%, lymphocytes 2.0%, monocytes 1.0%, blasts 97.0%), hemoglobin 4.9 g/dL, platelet count 39 × 109/L, creatinine 0.84 mg/dL, uric acid 11.5 mg/dL, and C-reactive protein (CRP) 0.07 mg/dL. Abdominal enhanced computed tomography (CT) revealed massive hepatosplenomegaly, bilateral kidney enlargement, and bowel wall thickening. The blast cells displayed two distinct cytomorphological populations: lymphoblasts and monoblasts. Immunophenotypic analysis showed that the blast cells commonly expressed CD19, CD15, and CD65. One third of the cells showed additional expression of CD20 and CD79a, while approximately 40% of the cells co-expressed CD14 and CD11b. Reverse transcription-polymerase chain reaction revealed KMT2A-MLLT10 fusion transcript. The patient was diagnosed with MPAL and remission induction therapy was initiated according to the Interfant-06 protocol [8].
Although massive hepatosplenomegaly progressively worsened and renal and intestinal blood flow decreased, these findings were mitigated after the initiation of therapy. Despite intensive care and administration of rasburicase, the patient developed tumor lysis syndrome. Renal function was maintained without renal replacement therapy, but he developed severe acute encephalopathy and late seizures that required phenobarbital (PB) and levetiracetam. Despite blast cells infiltrating the cerebrospinal fluid (CSF), bacteria and fungi were not detected in the CSF. The blast cells responded well to treatment and became undetectable in the peripheral blood on day 14. The fever decreased in accordance with the blast reduction; however, the fever again increased on day 11. With the administration of meropenem, vancomycin, and micafungin [MCFG; 6 mg/kg intravenously (IV) every 24 h], the fever gradually decreased. On day 14, CRP and beta-D-glucan levels increased up to 23.65 mg/dL and 105.6 pg/mL, respectively, and the fever again increased on day 18. As yeast was detected in the blood culture on day 25, MCFG was switched to liposomal amphotericin B (L-AMB; 5 mg/kg IV, every 24 h) on day 27. Based on the echocardiographic findings, endocarditis was ruled out. Skin redness was observed in the left lower quadrant (LLQ) of the abdomen and left wrist, where the arterial line had previously been placed. The wrist lesion was covered with crust (Fig. 1A). The cultured blood specimen showed smooth and waxy yeast-like colonies appearing on potato dextrose agar and turned black on day 32 (Fig. 2), suggesting the presence of Exophiala species. Sequence analysis of the internal transcribed spacer region confirmed E. dermatitidis and the fungus was also detected in the skin of the left wrist, stool, and endotracheal aspirate. However, E. dermatitidis was not detected from the skin culture from the abdominal lesion. The patient was diagnosed with fungemia and skin infection due to E. dermatitidis, and voriconazole (VRCZ) was added at a dose of 9 mg/kg IV and administered every 12 h; the dosage was further adjusted based on the results of therapeutic drug monitoring. Despite L-AMB and VRCZ administration and recovery of normal hematopoiesis, E. dermatitidis was repeatedly detected in the blood cultures. However, we were hesitant to remove the tunneled central venous catheter (CVC) due to multiple drug administrations for systemic management and difficulty in gaining vascular access. After approval by the Institutional Ethics Board, we initiated ethanol lock therapy (ELT) as a catheter salvage strategy on day 43. Both lumens of the tunneled catheter were instilled with a dose of 1 mL of 25% ethanol for 1–2 h every day [9]. Blood culture became negative 4 days after the commencement of ELT. Although the skin lesion on the left wrist improved without debridement, the abdominal lesion gradually enlarged and became black, reaching a diameter of approximately 8 cm. The edge of the lesion turned yellow, and the center was necrotized, which was consistent with the findings of the EG (Fig. 1B). Contrast-enhanced thoraco-abdominal CT showed an extensive necrotic mass with gas in the left lower abdomen connected to the small intestine and subcutaneous tissue adjacent to the skin (Fig. 3A). Although consolidations and multiple nodules were also observed in both lungs (Fig. 3B), the respiratory condition was stable without the need for mechanical ventilation. The EG of the LLQ of the abdomen and adjacent necrotic intestine was resected en bloc, without complications, on day 52 (Fig. 4A). Intraoperatively, beneath the transmural necrosis of the abdominal wall, there were two perforations in the necrotic small intestine that required resection and oral jejunostomy/distal ileostomy. Because the adjacent sigmoid colon was also segmentally necrotized, the necrotic lesion was resected and end-to-end anastomosis was performed. Massive defects of the skin and abdominal wall were managed using negative-pressure wound therapy (Renasys-GO™, Smith & Nephew GmbH). Histological examination showed that the resected small intestine almost lacked a mucosal layer structure, and Grocott-methenamine-silver-staining-positive fungi were found (Fig. 4B). Subcutaneous adipose tissue showed fat necrosis, and numerous fungi were also observed in the skin lesions. (Fig. 4C). On day 53, caspofungin (CPFG; 50 mg/m2 IV, every 24 h) was added because the isolated strain showed susceptibility to CPFG (the minimum inhibitory concentration being 0.25 μg/mL), and the trough level of VRCZ remained undetectable despite increasing the administration dose even after discontinuation of PB on day 61. The patient became afebrile on day 61 and his general condition improved. The highest value of beta-D-glucan (17,980 pg/mL) was seen on day 63, and the levels decreased thereafter. On day 66, the stomata and muscle layers were closed without complications. Subsequently, the skin defect was closed on day 107. ELT was continued until the removal of the CVC on day 72, without recurrence of fungemia. No fungi were detected at the tip of the CVC. The CRP level became normal just before removing the CVC, following which the administration of VRCZ, L-AMB, and CPFG was continued.
Discussion and conclusions
The cause of disseminated E. dermatitidis mycosis involving fungemia, EG, and pneumonia in the current MPAL case may be multifactorial. Remarkable hepatosplenomegaly may have caused intestinal ischemia, making the tissue vulnerable to infections. Interfant-06 therapy targeting both myeloid and lymphoid cells is indispensable for MPAL. In this case though the patient responded well, it resulted in severe neutropenia and lymphocytopenia. The patient developed fungemia with skin lesions during prolonged and profound neutropenia and lymphocytopenia. We initially suspected candidiasis, but the color of the colony and biphasic development suggested Exophiala species; the molecular analysis then confirmed E. dermatitidis. Considering that E. dermatitidis was also detected in the skin of the left wrist, stool, and endotracheal aspirate, we speculate that E. dermatitidis invaded through small erosion of the previous arterial line in the left wrist, progressed systemically as fungemia, developed pneumonia, colonized the intestine with ischemic damage, and then extended to the surrounding skin. Another possible explanation may be that E. dermatitidis in the environment caused catheter-related bloodstream infection and then invaded the skin and adjacent intestines.
The previous study had reported that 8 out of 25 adult patients with systemic E. dermatitidis infection had a fatal outcome [10]. The outcome in immunocompromised hosts differs slightly; it was reported that 4 out of 5 adult patients with hematological malignancies survived after disseminated E. dermatitidis infection [11]. In comparison, E. dermatitidis infections in children are rare. Thirteen pediatric cases aged < 15 years have been previously reported (Table 1) [12,13,14,15,16,17,18,19,20,21,22,23,24]. The median age at diagnosis was 3.5 years (range 0.2–11). The underlying diseases included acute leukemia (n = 3), primary immunodeficiency (n = 1), human immunodeficiency virus infection (n = 1), and cystic fibrosis (n = 1). However, 5 children had no underlying conditions for fungal infection. Seven out of 8 children with underlying diseases developed fungemia and pneumonia, and 7 survived with antifungal agents with or without catheter removal [12,13,14,15, 22, 24]. The present case of MPAL also developed fungemia, pneumonia, and severe skin infection. Although multiagent antifungal treatment failed to improve the condition, the patient was successfully treated with ELT and surgical intervention. Notably, all the children without underlying conditions did not survive. It is difficult to draw conclusions from the limited number of case reports, and further studies are required to clarify the prognostic factors for E. dermatitidis infection.
To date, the treatment of E. dermatitidis has not been standardized. Based on previous reports, we administered L-AMB and VRCZ [25, 26]. Although posaconazole is also a therapeutic choice for phaeohyphomycosis, it is recommended only for children 2 years and above. A combinational antifungal therapy failed to eliminate E. dermatitidis from blood culture for several reasons. First, the trough level of VRCZ remained suboptimal even after the discontinuation of PB, which was assumed to result from rapid metabolism. In addition, Exophiala species. are known to form biofilms. Catheter removal may be recommended in cases with protracted fungemia; however, a catheter salvage strategy was considered in our case because of multiple drug administrations for systemic management and difficulty in vascular access. ELT has broad antimicrobial activity, including antifungal [27], and has been shown to affect biofilms in vitro; therefore, it is considered as an alternative treatment to conventional antibiotic therapy for catheter-related bloodstream infections. ELT has also been reported to be effective in children, including in hemato-oncology patients [27, 28]. Given that the blood culture became negative 4 days after the initiation of ELT in our case, ELT can be considered a promising option for managing refractory fungemia with CVC.
EG has been reported in both adults and children and occurs mostly in immunocompromised individuals. A review of 167 previously reported cases of EG showed that P. aeruginosa was detected in 74% of patients, and the remaining were caused by other microorganisms, including Pseudomonas maltophilia and Aeromonas hydrophila [4]. Fungal infections, such as Mucor pusillus and Candida albicans have also been reported to cause EG; however, so far, Exophiala species have not been reported as the causative agent. An 8-year-old male with acute myeloid leukemia undergoing allogeneic stem cell transplantation developed severe E. dermatitidis infection and bullous epidermolysis in which skin lesion became black, but the diagnosis of EG was not confirmed [21]. The Infection Working Group of the Italian Pediatric Hematology-Oncology Association reviewed 38 children with malignancies or bone marrow failure syndromes who developed EG [29]. P. aeruginosa was the major cause of EG in the pediatric hematology-oncology cohort, whereas no fungi were isolated. The perineal region is the most involved site; however, various parts of the body, including the face and trunk can also be affected [4, 29]. Although the mainstay of management for EG is antibiotic therapy, 60–70% of EG cases require surgical intervention [4, 29]. Because the EG in the abdomen in our case was large and the adjacent intestines were also involved, en bloc resection of the EG and intestines was required. A large defect in the abdominal wall was successfully managed with two-step closure and negative pressure wound therapy. We believed that this aggressive resection may have contributed to the source control.
In conclusion, E. dermatitidis caused severe systemic infections, including fungemia, pneumonia, and EG, in an infant with MPAL receiving intensive chemotherapy. Although disseminated E. dermatitidis mycosis can be fatal, we successfully managed it with multidisciplinary treatment consisting of multiagent antifungal treatment, ELT, and surgery. Nevertheless, to establish the optimal treatment for disseminated Exophiala mycosis, further studies are required.
Availability of data and materials
Not applicable.
Abbreviations
- CPFG:
-
Caspofungin
- CRP:
-
C-reactive protein
- CSF:
-
Cerebrospinal fluid
- CT:
-
Computed tomography
- CVC:
-
Central venous catheter
- EG:
-
Ecthyma gangrenosum
- ELT:
-
Ethanol lock therapy
- IV:
-
Intravenously
- L-AMB:
-
Liposomal amphotericin B
- LLQ:
-
Left lower quadrant
- MPAL:
-
Mixed-phenotype acute leukemia
- PB:
-
Phenobarbital
- VRCZ:
-
Voriconazole
References
Woo PC, Ngan AH, Tsang CC, Ling IW, Chan JF, Leung SY, et al. Clinical spectrum of Exophiala infections and a novel Exophiala species Exophiala hongkongensis. J Clin Microbiol. 2013;51:260–7.
Vila A, Jahan C, Rivero C, Amadio C, Ampuero A, Pagella HH. Central line associated bloodstream infection (CLABSI) due to Exophiala dermatitidis in an adult patient: case report and review. Med Mycol Case Rep. 2019;24:33–6.
Kirchhoff L, Olsowski M, Rath PM, Steinmann J. Exophiala dermatitidis: key issues of an opportunistic fungal pathogen. Virulence. 2019;10:984–98.
Vaiman M, Lazarovitch T, Heller L, Lotan G. Ecthyma gangrenosum and ecthyma-like lesions: review article. Eur J Clin Microbiol Infect Dis. 2015;34:633–9.
Kikuchi N, Nakao H, Matsumoto Y, Yoshida K, Okai M, Kawai T, et al. Ecthyma gangrenosum in an infant with neutropenia. Int J Hematol. 2021;113:3–4.
Avolio M, La Spisa C, Moscariello F, De Rosa R, Camporese A. Aeromonas hydrophila ecthyma gangrenosum without bacteraemia in a diabetic man: the first case report in Italy. Infez Med. 2009;17:184–7.
Jiang Y, Al-Hatmi AM, Xiang Y, Cao Y, van den Ende AH, Curfs-Breuker I, et al. The concept of ecthyma gangrenosum illustrated by a Fusarium oxysporum infection in an immunocompetent individual. Mycopathologia. 2016;181:759–63.
Pieters R, De Lorenzo P, Ancliffe P, Aversa LA, Brethon B, Biondi A, et al. Outcome of infants younger than 1 year with acute lymphoblastic leukemia treated with the interfant-06 protocol: results from an international Phase III randomized study. J Clin Oncol. 2019;37:2246–56.
Raad I, Chaftari AM, Zakhour R, Jordan M, Al Hamal Z, Jiang Y, et al. Successful salvage of central venous catheters in patients with catheter-related or central line-associated bloodstream infections by using a catheter lock solution consisting of minocycline, EDTA, and 25% ethanol. Antimicrob Agents Chemother. 2016;60:3426–32.
Patel AK, Patel KK, Darji P, Singh R, Shivaprakash MR, Chakrabarti A. Exophiala dermatitidis endocarditis on native aortic valve in a postrenal transplant patient and review of literature on E. dermatitidis infections. Mycoses. 2013;56:365–72.
Watanabe N, Gotoh A, Shirane S, Hamano Y, Hirai Y, Shimizu M, et al. Breakthrough Exophiala dermatitidis infection during prophylactic administration of micafungin during second umbilical cord blood transplantation after graft failure. Transpl Infect Dis. 2018;20: e12833.
Kusenbach G, Skopnik H, Haase G, Friedrichs F, Döhmen H. Exophiala dermatitidis pneumonia in cystic fibrosis. Eur J Pediatr. 1992;151:344–6.
Kabel PJ, Illy KE, Holl RA, Buiting AG, Wintermans RG. Nosocomial intravascular infection with Exophiala dermatitidis. Lancet. 1994;344:1167–8.
Blaschke-Hellmessen R, Lauterbach I, Paul KD, Tintelnot K, Weissbach G. Detection of Exophiala dermatitidis (Kano) De Hoog 1977 in septicemia of a child with acute lymphatic leukemia and in patients with cystic fibrosis. Mycoses. 1994;37(Suppl 1):89–96 (German).
Nachman S, Alpan O, Malowitz R, Spitzer ED. Catheter-associated fungemia due to Wangiella (Exophiala) dermatitidis. J Clin Microbiol. 1996;34:1011–3.
Chang X, Li R, Yu J, Bao X, Qin J. Phaeohyphomycosis of the central nervous system caused by Exophiala dermatitidis in a 3-year-old immunocompetent host. J Child Neurol. 2009;24:342–5.
Hong KH, Kim JW, Jang SJ, Yu E, Kim EC. Liver cirrhosis caused by Exophiala dermatitidis. J Med Microbiol. 2009;58:674–7.
Alabaz D, Kibar F, Arikan S, Sancak B, Celik U, Aksaray N, et al. Systemic phaeohyphomycosis due to Exophiala (wangiella) in an immunocompetent child. Med Mycol. 2009;47:653–7.
Li DM, Li RY, de Hoog GS, Sudhadham M, Wang DL. Fatal Exophiala infections in China, with a report of seven cases. Mycoses. 2011;54:e136–42.
Hu B, Li S, Hu H, Chen T, Guo X, Zhang Z, et al. Central nervous system infection caused by Exophiala dermatitidis in a case and literature review. Zhonghua Er Ke Za Zhi. 2014;52:620–4 (Chinese).
Tanuskova D, Horakova J, Buzassyova D, Poczova M, Bodova I, Svec P, et al. A case of Exophiala dermatitidis infection in a child after allogeneic stem cell transplantation: case report and literature review of paediatric cases. JMM Case Rep. 2017;4: e005102.
Suzuki T, Yamanaka T, Aizawa Y, Horikoshi Y. Catheter-related bloodstream infection caused by Exophiala dermatitidis in a 2-year-old girl. J Pediatr Infect Dis Immunol. 2018;30:33–7 (Japanese).
Imanaka Y, Taniguchi M, Doi T, Tsumura M, Nagaoka R, Shimomura M, et al. Inherited CARD9 deficiency in a child with invasive disease due to Exophiala dermatitidis and two older but asymptomatic siblings. J Clin Immunol. 2021;41:975–86.
Kumar A, Nandakumar A, Nair S, Singh A, Shashindran N, Thulasidharan S, et al. Exophiala dermatitidis as a cause of central line associated bloodstream infection in an infant: case report and literature review. Rev Iberoam Micol. 2021;38:12–5.
Yu HY, Qu TT, Yang Q, Hu JH, Sheng JF. A fatal case of Exophiala dermatitidis meningoencephalitis in an immunocompetent host: a case report and literature review. J Infect Chemother. 2021;27:1520–4.
Yoshida T, Tachita T, Fujinami H, Oshima Y, Sasaki H, Marumo Y, et al. Exophiala dermatitidis fungemia diagnosed using time-of-flight mass spectrometry during chemotherapy for malignant lymphoma and successful treatment with voriconazole. Intern Med. 2019;58:2219–24.
Chiba M, Yonekura T, Kaji T, Amae S, Tazuke Y, Oowari M, et al. Ethanol lock therapy in pediatric patients: a multicenter prospective study. Pediatr Int. 2020;62:379–85.
Ashkenazi-Hoffnung L, Shecter N, De-Vries I, Levy I, Scheuerman O, Yarden-Bilavsky H, et al. Factors predicting efficacy of ethanol lock therapy as catheter salvage strategy for pediatric catheter-related infections. Pediatr Blood Cancer. 2021;68: e28856.
Muggeo P, Zama D, Decembrino N, Onofrillo D, Frenos S, Colombini A, et al. Ecthyma gangrenosum in children with cancer: diagnosis at a glance: a retrospective study from the infection working group of Italian pediatric hematology oncology association. Pediatr Infect Dis J. 2022;41:238–42.
Acknowledgements
We thank Dr. Takashi Yaguchi and the Medical Mycology Research Center, Chiba University Chiba, Japan, for undertaking the susceptibility testing and confirmatory identification. We would also like to thank Editage [http://www.editage.com] for editing and reviewing this manuscript for English language.
Funding
The authors received no specific funding for this work.
Author information
Authors and Affiliations
Contributions
RN performed a literature search and drafted the first version of the manuscript. MA and HY were responsible for the study design and revised the manuscript. KY, TN, TU, and NM advised this case report from the perspectives of pediatric surgery, radiology, pathology, and infectious diseases professionals, respectively. DH supervised the completion of this case report and substantively revised the manuscript. All authors read and approved the final manuscript.
Corresponding author
Ethics declarations
Ethics approval and consent to participate
The study was conducted in accordance with the Declaration of Helsinki and the national and institutional standards. The guardian of the patient provided written informed consent for the anonymous collection and use of data for research purposes.
Consent for publication
The guardian of the patient signed the consent form and agreed to publish this report. A copy of the signed consent form is available for review by the Editor of this journal.
Competing interests
The authors declare that they have no competing interests.
Additional information
Publisher's Note
Springer Nature remains neutral with regard to jurisdictional claims in published maps and institutional affiliations.
Rights and permissions
Open Access This article is licensed under a Creative Commons Attribution 4.0 International License, which permits use, sharing, adaptation, distribution and reproduction in any medium or format, as long as you give appropriate credit to the original author(s) and the source, provide a link to the Creative Commons licence, and indicate if changes were made. The images or other third party material in this article are included in the article's Creative Commons licence, unless indicated otherwise in a credit line to the material. If material is not included in the article's Creative Commons licence and your intended use is not permitted by statutory regulation or exceeds the permitted use, you will need to obtain permission directly from the copyright holder. To view a copy of this licence, visit http://creativecommons.org/licenses/by/4.0/. The Creative Commons Public Domain Dedication waiver (http://creativecommons.org/publicdomain/zero/1.0/) applies to the data made available in this article, unless otherwise stated in a credit line to the data.
About this article
Cite this article
Nakatani, R., Ashiarai, M., Yoshihara, H. et al. Multidisciplinary management of disseminated Exophiala dermatitidis mycosis in an infant with mixed phenotype acute leukemia: a case report. BMC Infect Dis 22, 797 (2022). https://doi.org/10.1186/s12879-022-07773-w
Received:
Accepted:
Published:
DOI: https://doi.org/10.1186/s12879-022-07773-w